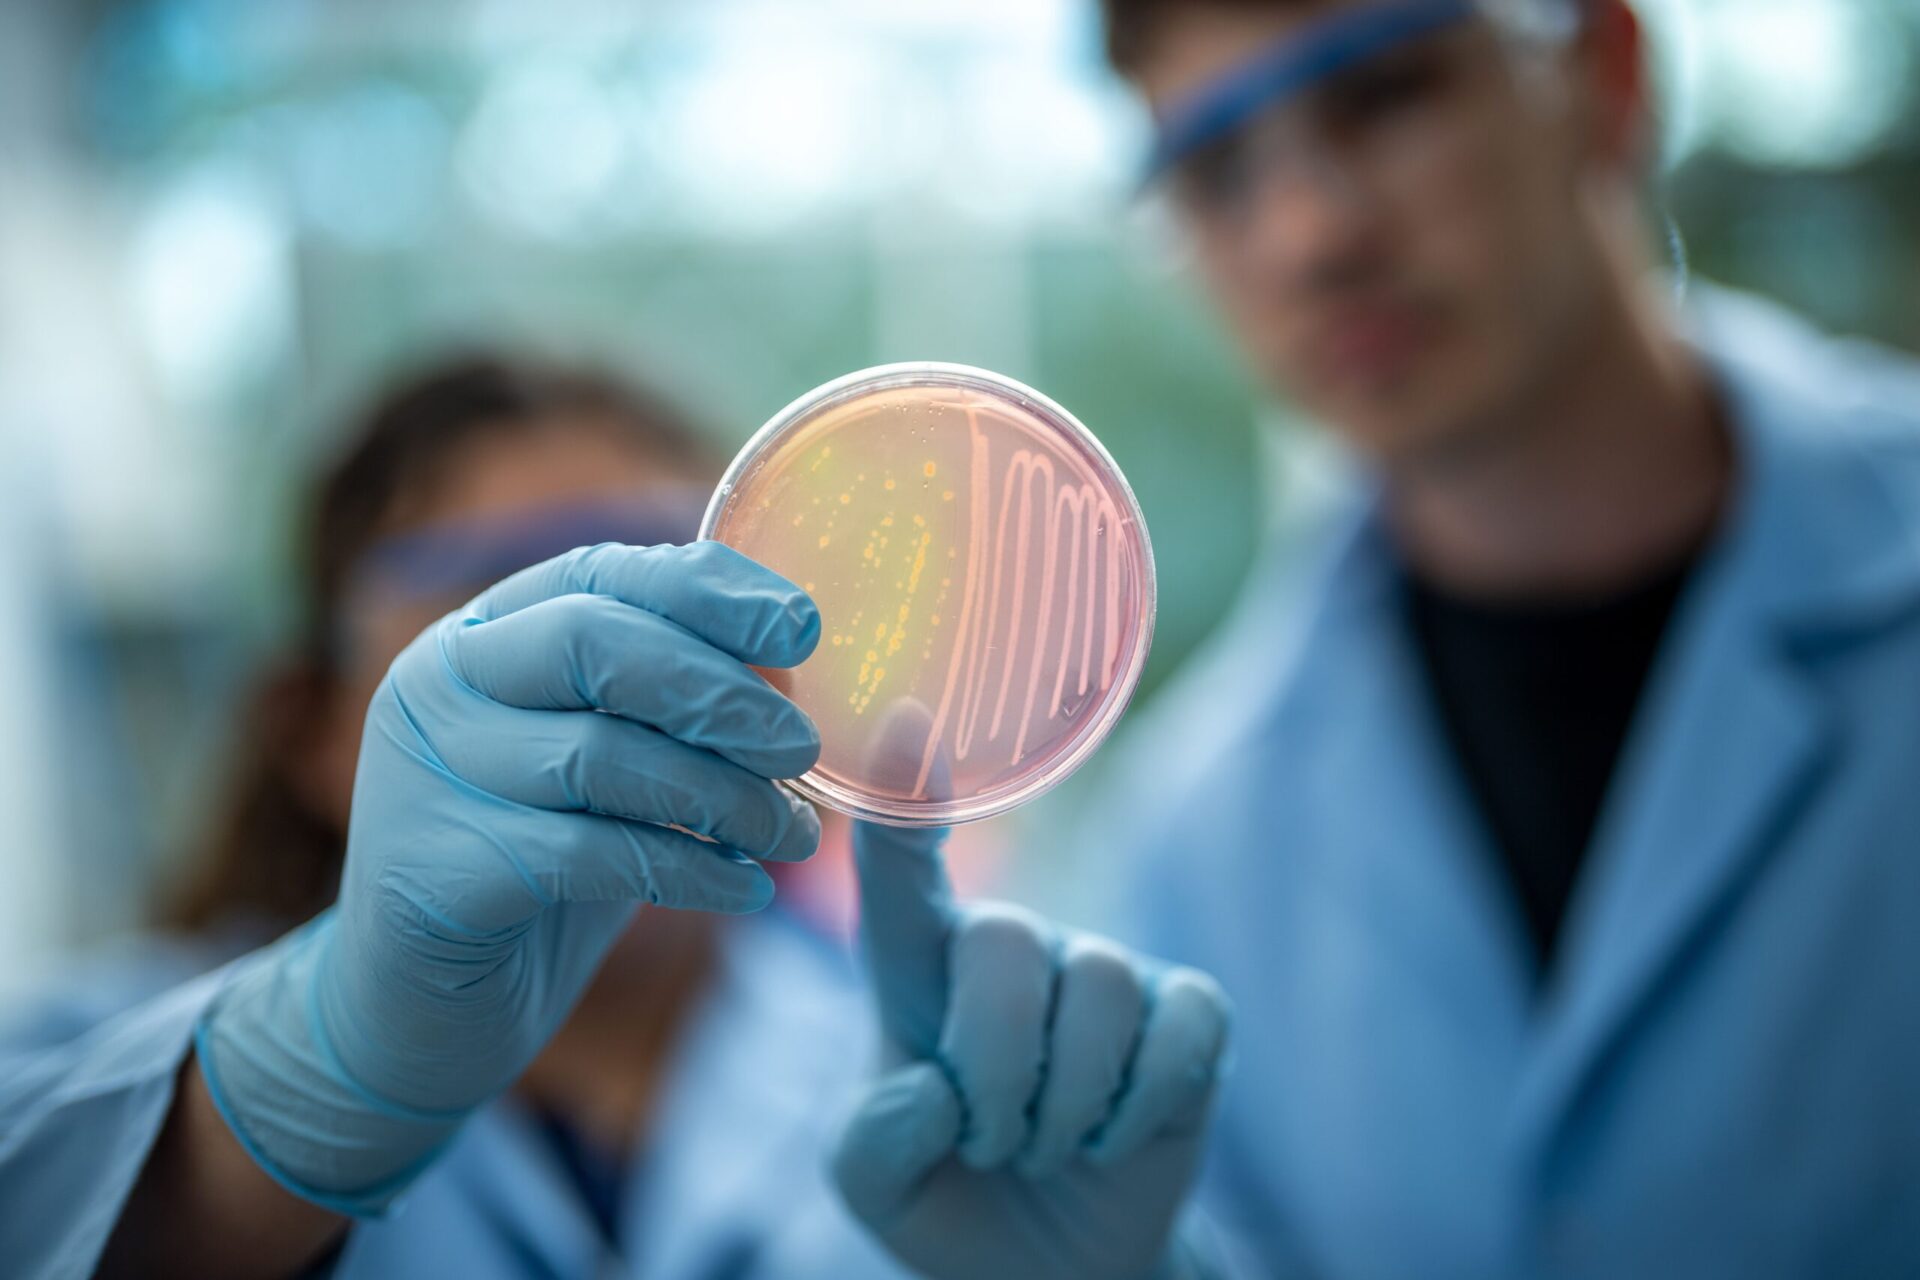

Biology
Major (BA, BS) | Minor
Biology at North Park
Studying biology teaches you to use the scientific method to uncover nature’s mysteries through topics like molecular biology, anatomy, botany, zoology, ecology, and microbiology. A biology major prepares you for advanced studies in medicine, genetics, biotechnology, science education, and more. At North Park, hands-on laboratory components and in-depth field experiences solidify the connections between theory and practice.
Request Information
"*" indicates required fields
Featured course
BIOL 2280–Introduction to Botany
Survey of the plant kingdom and related organisms from algae to flowering plants. Identification of campus vascular plants. Basic life processes including photosynthesis, plant development, reproductive cycles, flowering and fruiting responses, and the ecological importance and conservation of plants will be studied.
Research opportunities
Each year, the biology department offers for-credit trips to places like the Bahamas and Taiwan, where students explore local ecology and culture alongside North Park professors and local experts.
Students can also choose to participate in field research opportunities at the Shedd Aquarium, Morton Arboretum, and Au Sable Institute.
Research happens on campus too where students can conduct original hands-on research under the guidance of experienced faculty mentors.

I love being at an institution where I can teach rigorous science in a setting that values questions of meaning, faith, justice, and vocation.
—Dr. Caitlin Wong Hickernell, Assistant Professor of BiologyContact
College of Arts and Sciences
Division of Sciences
Johnson Center
5141 N. Christiana Ave.
Chicago, IL 60625
artsandsciences@northpark.edu
(773) 244-5660


